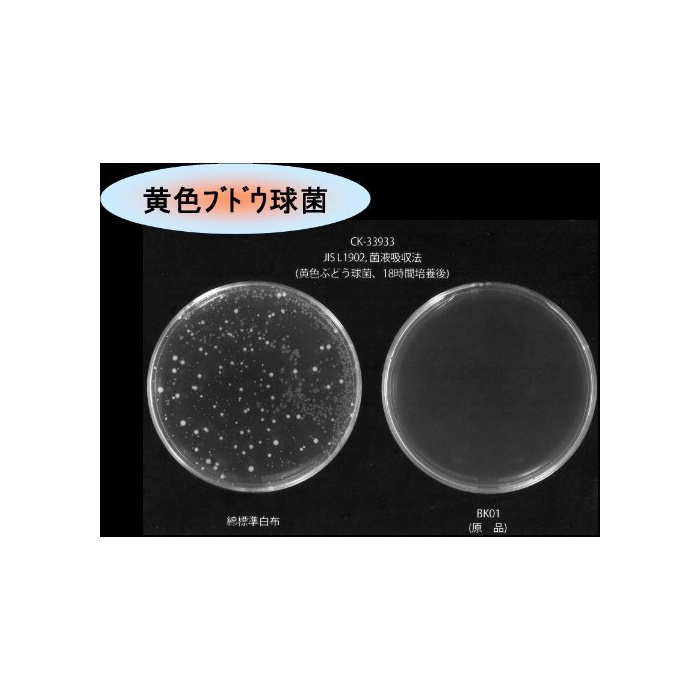

PRODUCT NAME
기침《스이》 기침스이 나노도타루힐 교환용 300ml
PRODUCT CODE: PROD50130478
PRODUCT INFORMATION
원본상품명:セキスイ ナノトタル詰替え用 300ml
본체 사이즈 (폭X(길이)깊이X높이) :9×5.6×20.5cm
본체 중량 :315g
내용량:300ml
원산국:일본
Technical Details
Product Details
Product Dimensions
Package Dimensions
Width : 3.35 inch
Height : 1.97 inch
Length : 8.27 inch
Item Weight: 11.04 ounce (View shipping rates and policies)
Shipping Weight: 11.36 ounce (View shipping rates and policies)
ASIN : B009HMV2ZE